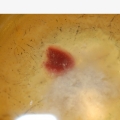

Przylecą z drugiego końca świata, zamieszkają u legnickich rodzin, by poczuć klimat polskiego domu i poznać smaki naszej kuchni. Od 20 do 25 lipca w Legnicy przebywać będzie około 700 uczestników Światowych Dni Młodzieży. Głównie będą to pielgrzymi ze Stanów Zjednoczonych. Na gości z zagranicy czeka wiele atrakcji, zwiedzą nie tylko Legnicę, ale także pojadą do Bazyliki w Krzeszowie oraz do stolicy Dolnego Śląska - Wrocławia. Przygotowując program pobytu, staraliśmy się wziąć pod uwagę wszystkie prośby i sugestie, z którymi pielgrzymi zwracali się do nas drogą mailową.
Update Required To play the media you will need to either update your browser to a recent version or update your Flash plugin.
Uczestnicy Światowych Dni Młodzieży od 20 do 25 lipca zamieszkają u legnickich rodzin. Później wyruszą do Krakowa na spotkanie młodych z całego świata z papieżem Franciszkiem. Program pobytu pielgrzymów w Diecezji Legnickiej TUTAJ.